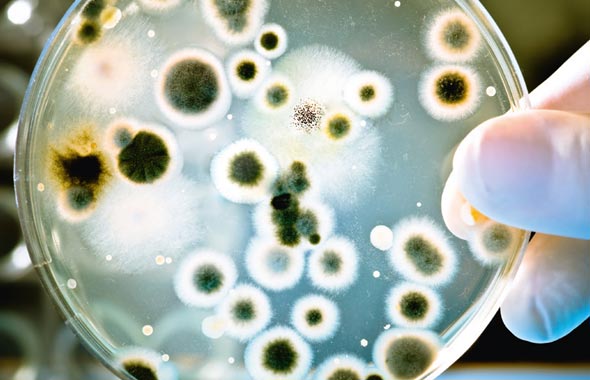
Wie kann ich Schimmel beseitigen? Schimmelbeseitigung und -prävention durch die SPEIDEL System Trocknung GmbH

Wasserschaden und Brandschaden - Unsere Themen
Aktuelles
SIE BRAUCHEN HILFE?
24-Stunden-Notdienst – mit der kostenfreien Service-Nummer
0800 – 400 0800
oder schreiben Sie uns eine Mail
News aus der Welt der Brandschaden- & Wasserschadensanierung
Herzlich willkommen bei der SPEIDEL System Trocknung GmbH, Ihrem zuverlässigen Partner für professionelle Brandschaden – & Wasserschadensanierung.
Hier finden Sie News aus der Welt der Brandschaden- & Wasserschadensanierung, sowie aktuelle Informationen rund um unser Unternehmen.